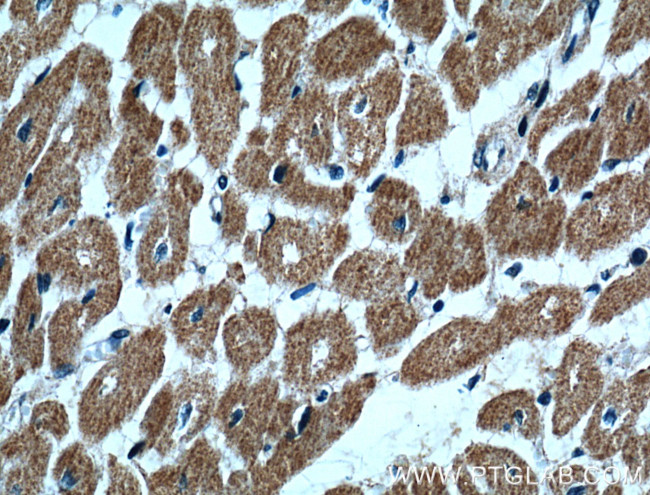
UBE2O Antibody in Immunohistochemistry (Paraffin) (IHC (P))
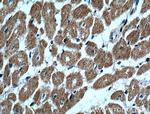
UBE2O Antibody in Immunohistochemistry (Paraffin) (IHC (P))

Search
Proteintech
UBE2O Polyclonal Antibody
{{$productOrderCtrl.translations['antibody.pdp.commerceCard.promotion.promotions']}}
{{$productOrderCtrl.translations['antibody.pdp.commerceCard.promotion.viewpromo']}}
{{$productOrderCtrl.translations['antibody.pdp.commerceCard.promotion.promocode']}}: {{promo.promoCode}} {{promo.promoTitle}} {{promo.promoDescription}}. {{$productOrderCtrl.translations['antibody.pdp.commerceCard.promotion.learnmore']}}
产品信息
15812-1-AP
种属反应
宿主/亚型
分类
类型
抗原
偶联物
形式
浓度
规格
纯化类型
保存液
内含物
保存条件
运输条件
产品详细信息
Immunogen sequence: SSDSGPEAG SQRLLFSHDL VSGRYRGSVH FGLVRLIHGE DSDSEGEEEG RGSSGCSEAG GAGHEEGRAS PLRRGYVRVQ WYPEGVKQHV KETKLKLEDR SVVPRDVVRH MRSTDSQCGT VIDVNIDCAV KLIGTNCIIY PVNSKDLQHI WPFMYGDYIA YDCWLGKVYD LKNQIILKLS NGARCSMNTE DGAKLYDVCP HVSDSGLFFD DSYGFYPGQV LIGPAKIFSS VQWLSGVKPV LSTKSKFRVV VEEVQVVELK VTWITKSFCP GGTDSVSPPP SVITQENLGR VKRLGCFDHA QRQLGERCLY VFPAKVEPAK IAWECPEKNC AQGEGSMAKK VKRL (48-339 aa encoded by BC007822)
靶标信息
E2/E3 hybrid ubiquitin-protein ligase that displays both E2 and E3 ligase activities and mediates monoubiquitination of target proteins (PubMed:23455153, PubMed:24703950). Negatively regulates TRAF6-mediated NF-kappa-B activation independently of its E2 activity (PubMed:23381138). Acts as a positive regulator of BMP7 signaling by mediating monoubiquitination of SMAD6, thereby regulating adipogenesis (PubMed:23455153). Mediates monoubiquitination at different sites of the nuclear localization signal (NLS) of BAP1, leading to cytoplasmic retention of BAP1. Also able to monoubiquitinate the NLS of other chromatin-associated proteins, such as INO80 and CXXC1, affecting their subcellular location (PubMed:24703950). Acts as a regulator of retrograde transport by assisting the TRIM27:MAGEL2 E3 ubiquitin ligase complex to mediate 'Lys-63'-linked ubiquitination of WASHC1, leading to promote endosomal F-actin assembly (PubMed:23452853). [UniProt]
仅用于科研。不用于诊断过程。未经明确授权不得转售。
生物信息学
蛋白别名: (E3-independent) E2 ubiquitin-conjugating enzyme; E2/E3 hybrid ubiquitin-protein ligase UBE2O; Ubiquitin carrier protein O; ubiquitin conjugating enzyme E2O; Ubiquitin-conjugating enzyme E2 O; Ubiquitin-conjugating enzyme E2 of 230 kDa; Ubiquitin-conjugating enzyme E2-230K; Ubiquitin-protein ligase O; unnamed protein product
基因别名: E2-230K; KIAA1734; UBE2O
UniProt ID: (Human) Q9C0C9
Entrez Gene ID: (Human) 63893